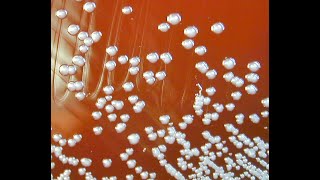

КАК ЗАБЕРЕМЕНЕТЬ ПРИ АДЕНОМИОЗЕ
Аденомиоз - это состояние, когда ткань, подобная эндометрию (внутренней оболочке матки), проникает в стенки матки. Это может привести к различным проблемам при зачатии и беременности. Однако, справедливо отметить, что каждый случай аденомиоза индивидуален, и результаты могут различаться у разных женщин.
Если у вас диагностирован аденомиоз и вы планируете забеременеть, важно обратиться за консультацией к специалисту, такому как гинеколог-репродуктолог или специалист по репродуктивной медицине. Он сможет оценить ваше состояние и предложить наилучшие решения для реализации желания иметь ребенка.
Лечение аденомиоза может включать медикаментозную терапию, хирургическое вмешательство или комбинацию этих методов. Удаление узлов аденомиоза может повысить вероятность успешного зачатия. Однако, каждый случай требует индивидуального подхода, и необходимо следовать рекомендациям врача.
Важно также помнить, что беременность при аденомиозе может сопровождаться рисками. Узлы аденомиоза могут увеличиваться и вызывать проблемы, такие как выкидыши или преждевременные роды. Регулярные визиты к врачу и медицинское наблюдение помогут своевременно выявлять любые проблемы и минимизировать риски.
Однако, каждый случай аденомиоза уникален, и результаты могут различаться. Поэтому, если вы планируете забеременеть при наличии аденомиоза, наилучшим решением будет обратиться за консультацией к специалисту, который сможет провести необходимое обследование и помочь вам принять информированное решение о вашем планировании беременности.
902 Аденомиоз и беременность
Аденомиоз. Возможна ли беременность при аденомиозе 2 степени? Отвечает Гузов И.И.
Как увеличить шансы забеременеть при эндометриозе?
Как будет протекать беременность с эндометриозом?
Аденомиоз - Людмила Шупенюк и Волык Нелла
Эндометриоз. Как сохранить шанс на беременность.
Можно ли забеременеть при эндометриозе?
Аденомиоз - надо ли лечить?